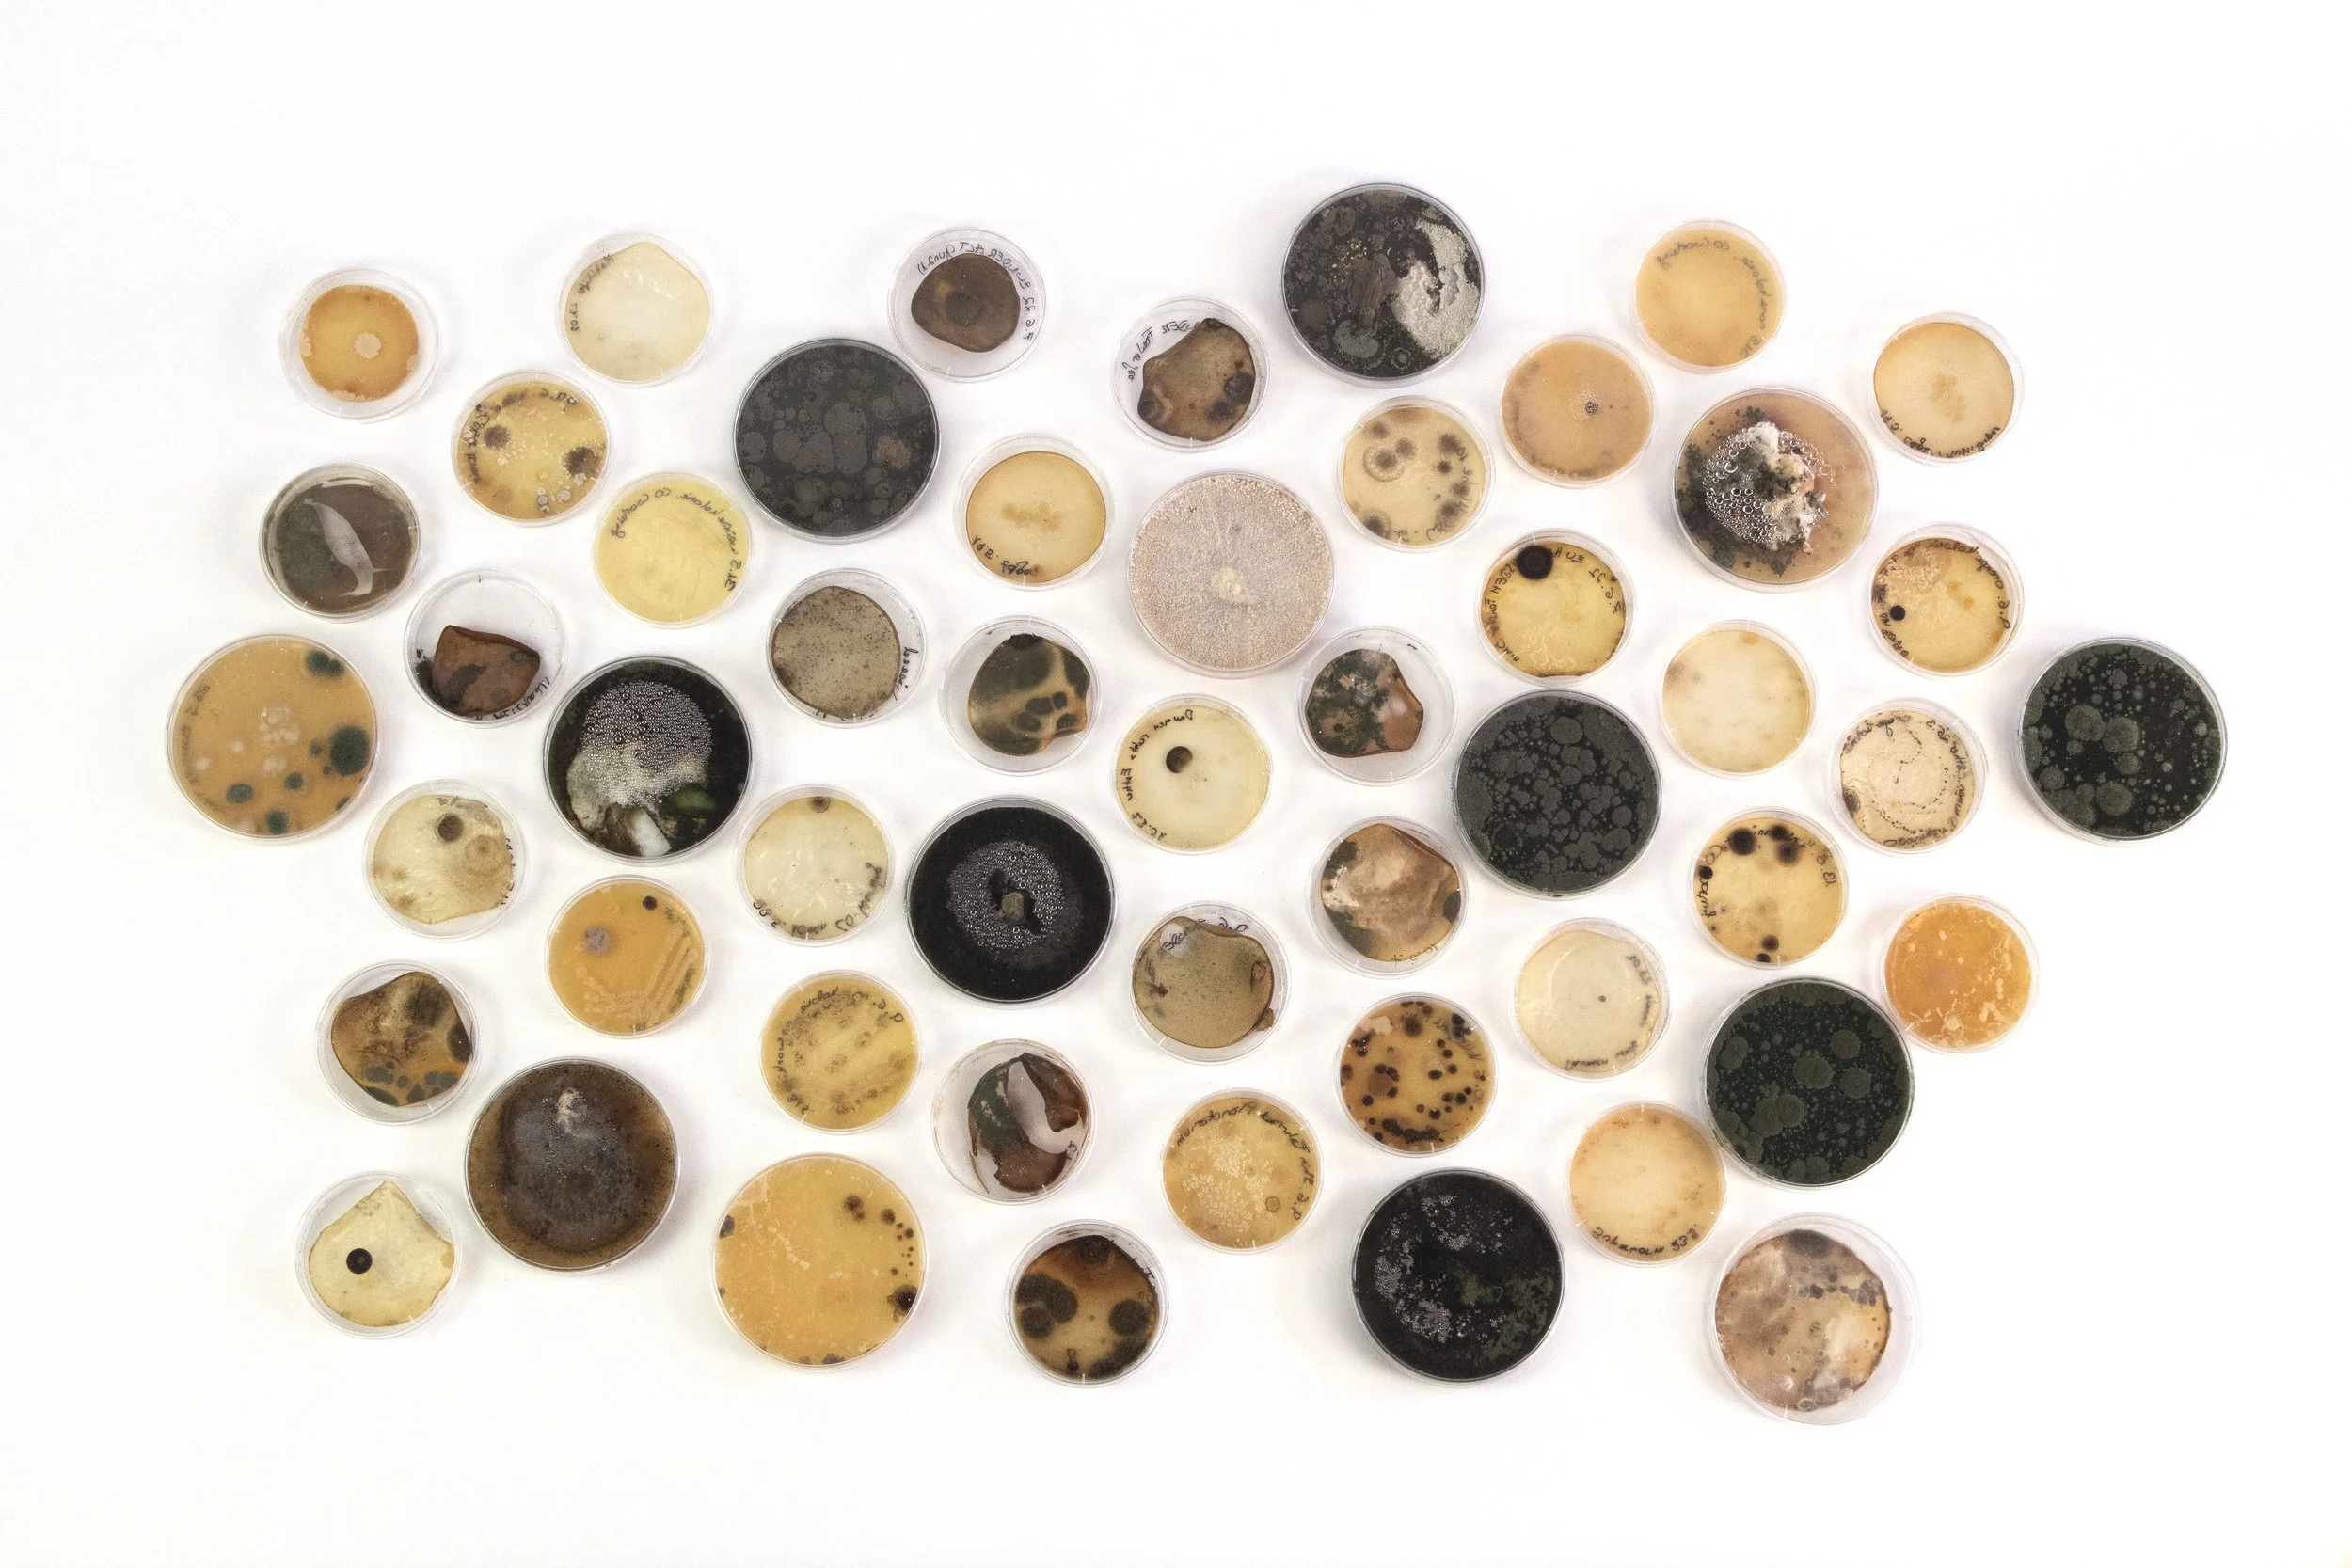
Interspecies Design Studio_Other_Moulds.jpg

Researching Interspecies Design
With As designers, we most commonly work with materials that as humans with a heterotrophic metabolism, we can not produce ourselves. Therefore the things we design can only be produced in dependence on and with the help of other organisms. „Founding an Interspecies Design Studio“ looks at the complex relationships, challenges and opportunities of working with other species to develop a material future for surviving on this planet. Creating a workspace to welcome fungi, airborne bacteria, darkling beetles as well as algae, the project sets out to continue to research the complexities of interspecies relationships.